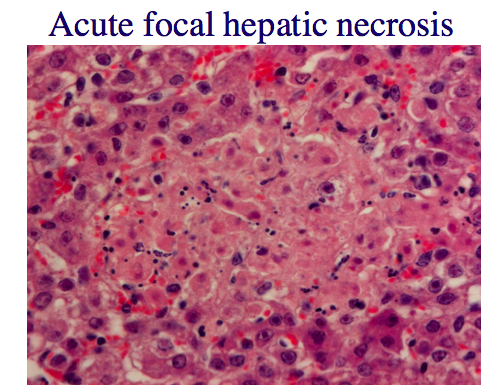

Hvordan forløber drægtighedsperioden hos en hoppe?

Hvilke årsager er der til aborter og dødsfødte i heste?
De hyppigste:

Hvad kan give abort pga. sygdom hos hoppen?
Hvad kan give abort pga. sygdom hos føllet?
Non-infektiøse årsager:
Infektiøse tilstande:
Hvorfor og hvordan forløber en umbilical cord torsion/navlestrengs torsion?

Hvorfor giver drægtighed med tvillinger abort?
Nævn nogle former for malformationer som kan ses hos hest?
Hvilke patologiske fund ses der ved Equine herpesvirus type 1?
Hvilke symptomer ses ved bakteriel infektion hos hest?

Hvilke undersøgelser er vigtige ved abort og hvad skal sendes i til laboratoriet?
Skal sendes ind:
Hvor gammel skal fosteret være, før man kan sende til det ind til diagnostik, og hvorfan kan det først sendes ind så sent? (får)
Fosteret skal være 80 dage.
Før de 80 dage:

Infektion af fosteret under drægtighed, kan resultere i? (får)
Hvad er en mummufikation?
Et udtryk for at foster har været tilbage holdt i en periode i uterus.
Hvilken sygdom giver mummifikationer hos svin?
Parvovirus giver små mummier, store mummier, forskellige stadier af mummificering i fostrene. Nogle vil dog bare være døde uden at være mummificerede.
Hvad er opklaringsprocenten i laboratoriet for aborter?
Opklaringsprocent er ca. 50 % alle steder i verden. Man kan altså ikke love nogen, at man finder årsagen hvis man sender fostret til analyse.
Man kan ikke på baggrund af et foster stille en besætningsdiagnose, da mange af patogenerne, der giver besætningproblemer og som er nævnt her også kan give sporadiske aborter. - Bortset fra neospora hos kvæg!!!! Dette er altid et besætningsproblem eller toxoplasma hos får. Men T. pyogenes fx. giver sporadiske aborter, så man kan ikke sige at det er et besætningsproblem.
Hvor skal man se efter læsioner på en hesteplacenta?
Omkring åbningen til cervix, det stjerneformede ar, fordi infektioner hos hest ofte er ascenderende
Hvilke agens er klassisk for multifokale nekroser og kalcifikatiober i cotylodonerne hos små drøvtyggere?
De hvide prikker i kotelydonet er karateristisk for protozoer. Hos små drøvtygger ses det ved T. gondii og sarcocyster.
Hvilken bakterie giver ofte dermatitis hos fostrene hos får?
Fusobacterium Necrophorum
Hvad er anasarca og hvilke problemer opstår der ved dette syndrom?
Anasarca er generaliseret ødem.
Fostrene kan ikke fødes. De kommer ofte ikke engang i fødselsvejen, men sidder fast i den indre bækkenåbning. Moderen går i fødsel uden man opdager det og så rådner de inden i moderen.
Hvad ser vi ved infektion med Listeria monocytogenes?
Dissemineret nekrotiserende pneumoni
Dissemineret nekrotiserende hepatitis
Hvad ser vi ved infektion med Fusobacterium necrophorum?
Kronisk multifokal nekrotiserende hepatitis
Hvilke årsager til abort er hyppigt hos kvæg?
Hvilke årsager til abort er hyppigst hos får og ged?
Salmonella sp. Ex. S. Dublin og S. typhimurium, giver abort hos kvæg. Men hvilken form for abort? Abortstorme eller sporadiske aborter?
Sporadiske aborter